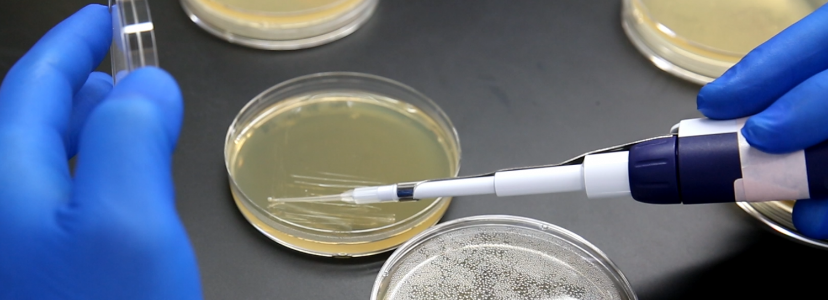

Students investigate locations they believe harbor cellulose-digesting microbes, collect samples, isolate them on selective media, and screen them for cellulase activity. These novel microbes may be useful for the production of cellulosic ethanol. In the process they learn about plating techniques, serial dilutions, symbiotic relationships and enzyme specificity. Two methods are provided, one focusing on isolation of pure microbial strains, the other focusing on finding symbiotic communities of microbes.

Subjects
Agriculture
Engineering
Topics
Biodiversity & Evolution
Ecosystems
Fermentation & Enzymes
Concepts/Skills
Decomposition, respiration, biomolecules, enzymes, microbial ecology, data analysis, scientific argumentation
Prior Knowledge
Symbiotic relationships, types of carbohydrates, basic cell wall structure, enzyme structure and function
Time Required
Five to seven 50-minute class periods over 12-18 days (can be adapted to short times)
Required Supplies
Community method: Erlenmeyer flasks, aluminum foil, cellulosic biomass (i.e. wood chips, corn stover, saw dust, etc), Petri dished (optional), Carboxymethyl Cellulose (optional), Congo Red (optional)
Isolation method: Centrifuge tubes, Petri Dishes, Carboxymethyl Cellulose (CMC), Microcrystalline Cellulose (optional), Agar, Small pestles, Bacteria spreaders, Inoculating loops, PBS Buffer or TRIS buffer, Congo Red, P200 pipette tips, 10uL dispensing micropipettes, Parafilm, Ethanol, Bleach, NaCl. **See activity package for amounts and supplier details